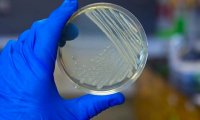
Земные микроорганизмы выжили в условиях Марса‍

Экс-командир батальона "Север" допрошен в суде по "делу Немцова"
Московский окружной военный суд допросил сегодня экс-главу батальона "Север" по делу об убийстве политика Бориса Немцова. Алибек Делимханов прибыл в суд.

Московский окружной военный суд допросил сегодня экс-главу батальона "Север" по делу об убийстве политика Бориса Немцова. Алибек Делимханов прибыл в суд.

По завершению встречи с главой РФ Владимиром Путиным молдавский президент Игорь Додон рассказал о своей надежде на возможность выхода из соглашения об ассоциации с ЕС после ближайших выборов в...

Второй "черный ящик" найден на месте крушения турецкого грузового Boeing под Бишкеком. Об этом во вторник сообщила пресс-служба киргизского правительства.

По мнению президента РФ Владимира Путина, материалы о том, что избранный президент США Дональд Трамп несколько лет назад в Москве приглашал себе в номер девушек легкого поведения, сфабрикованы...

Английский футбольный клуб «Манчестер Сити» готов потратить 115 миллионов евро на приобретение нападающего «Барселоны» и сборной Аргентины Лионеля Месси. Об этом сообщает The Sun.

Впрочем, не лишним будет отметить, что эти теории и заявления еще не успели получить реального подтверждения со стороны представителей официальной медицины.

Депутаты Госдумы нового созыва стали вносить меньше инициатив, чем прежде: лишь 100 из 450 стали авторами законопроектов в осеннюю сессию, говорится в рейтинге законотворцев фонда ИСЭПИ.

По итогам этой работы специалисты из Британии сделали вывод, что конкретный день недели может быть напрямую связан с тем, как протекает родовой процесс у женщины и насколько болезненными ощущениями...

В России разгорается скандал, в орбиту которого оказались втянутыми глава «Роснефти» Игорь Сечин и руководитель «Транснефти» Николай Токарев. Подробности - в материале, размещенном на сайте...

Сегодня на сайте InoPressa был размещен материал, рассказывающий о задержании испанской полицией г-на Петера Вакки, который является «правой рукой» российского миллиардера Михаила Фридмана....

По их мнению, солярий продуцирует в 5-6 раз большее количество ультрафиолетового излучения, чем, например, солнечный свет на территории Норвегии. Этот факт также повышает риски развития онкологии.

Исполняющие обязанности глав регионов, которым в сентябре предстоят выборы, формируют региональные правительства из "варягов". Так поступили Дмитрий Миронов (Ярославская область), Игорь Васильев...

Согласно данным источников, на иллюстрациях к полученному компанией патенту присутствует устройство, которое сочетает в себе возможности планшета и смартфона.
Специалисты провели исследования с микробами сразу нескольких видов, в результате которых и было установлено, что ряд земных микроорганизмов демонстрирует способность к существованию без кислорода и...

Глава государства Владимир Путин поручил первому заместителю главы администрации президента Сергею Кириенко рассмотреть просьбу Совета по правам человека расширить функции Росприроднадзора. Авторы...

Госаудиторы проверили эффективность системы агрострахования с господдержкой. По их мнению, эта сфера переживает спад, агрострахование невыгодно хозяйствам, Минсельхоз затягивает сроки утверждения...

Девочка находилась на лестничной клетке на 3 этаже здания. Вызванным местными жильцами сотрудникам полиции девочка заявила, что ее имя Александра и что ей скоро исполнится 8 лет

Биржевые цены на бензин продолжили расти после новогодних праздников. Такая динамика необычна для начала года, поскольку зимой нефтекомпании снижают оптовые цены из-за стагнирующего спроса. Но в 2017...

Позднее на связь с родителями вышла и сама школьница. Она рассказала, что трое мужчин схватили ее возле ТЦ Грин, усадили в автомобиль и увезли в неизвестное ей место.

Министерство сельского хозяйства утвердило план законопроектной деятельности на 2017 год. Эксперты считают, что в данный момент наиболее актуальна законотворческая работа в области животноводства и,...